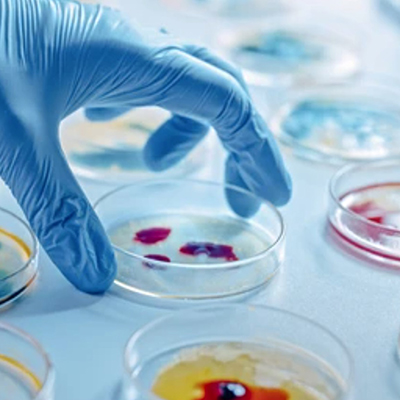
Medical Laborator/CONSUMABILE LABORATOR/Cutii Petri

CONSUMABILE LABORATOR
In aceasta categorie puteti gasi accesorii de laborator (instrumentar medical), utile in recoltarea probelor si realizarea de analize medicale, precum: recipient coprorecoltor; lame de microscop; exudat faringian; pipete serologice sterile; pipeta automata monocanal si multicanal; varfuri de pipeta; anse pentru inoculare; lanterna; agitator magnetic; criotuburi; casete histologice; pungi de recoltare; parafina histologica cu polimeri; ace de recoltare cu adaptor Luer Lock; vacuntaioner VSH; pungi pentru voma; sistem drenaj recipient; lantete de plastic twist-one; eprubete sumar urina; penseta lamele si membrane; spray pentru fizarea probelor citologice; inel metalic inchis cu mufa sau inel deschis cu mufa etc.
Vetro va pune la dispozitie o gama variata de consumabile de laborator. Toate produsele sunt realizate la standard de laborator si au preturi speciale.
CONSUMABILE LABORATOR - preturi incepand de la 0.60 lei
0151-LMN-10-RO Exsudat faringian steril, PRIMA, lemn + bumbac, 100 bucati
16,18 lei ( 19,58 lei cuTVA)
0934-SNU Garou medical mic PRIMA cu snur elastic si deblocare rapida, 10cm, negru
6,27 lei ( 7,59 lei cuTVA)- -15%
1068-ABS-500 Varfuri 200-1000ml, PRIMA, pentru autopipeta Eppendorf-Glison-Brand-Scorex, albastre, 500buc
11,54 lei 13,58 lei ( 13,96 lei cuTVA)
1207-13 Stativ Vacutainer din Plastic, Diametru Tub 13 mm, Alb, 265 x 126 x 75 mm
124,41 lei ( 150,54 lei cuTVA)
1960-6ML
1957-16x16 Punga transport probe biologice polietilena 16x16.5 cm cu fermoar zip-lock si buzunar documente, portocalie, set 100 bucati
59,67 lei ( 72,20 lei cuTVA)Livrare in 30 zile
2095 Pipeta serologica sterila 1 ml, gradata, din polistiren, de unica folosinta, pentru laborator si uz medical
0,78 lei ( 0,94 lei cuTVA)Livrare in 30 zile
2105-1000 Recipient probe anatomie patologica si plasma, 1000 ml
8,35 lei ( 10,10 lei cuTVA)Livrare in 2 zile
2105-500 Recipient plastic 500 ml pentru probe anatomie patologica din polipropilena, biologic periculos, alb/albastru
6,16 lei ( 7,45 lei cuTVA)Livrare in 2 zile
2381 Placi microtitrare, din polistiren transparent de calitatate, nesterile, cu fund in forma de U, pentru laborator, in cutie, 96 godeuri, 50 bucati
247,22 lei ( 299,14 lei cuTVA)Livrare in 30 zile- -15%
1068-GLB-1000 Varfuri 0-200ml, PRIMA, pentru autopipeta Eppendorf-Brand-Scorex, galbene, 1000buc
10,39 lei 12,22 lei ( 12,57 lei cuTVA)
1960-6ML-NB Vacutainer Biochimie rosu, fara aditiv, 6ml, 13x100ml, 100buc
33,44 lei ( 40,46 lei cuTVA)


RO
EN
BG
HU
FR
DE